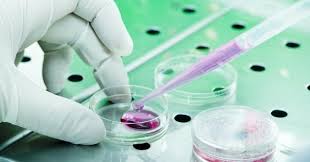

Antibiotici, la resistenza alla colistina, considerata l”ultima spiaggia’ nel campo degli antibiotici, è molto più diffuso di quanto pensassero gli esperti sia per dimensioni, con aree in cui il 100 per cento degli animali da allevamento ne è portatore, sia per diffusione, con esempi trovati ormai in tutto il mondo. A fare il punto, riporta la rivista Nature, sono state diverse presentazioni al meeting della American Society for Microbiology (ASM) di New Orleans.
La prima descrizione di un batterio con il gene mcr-1, quello appunto che rende inoffensiva la colistina, risale ad appena 18 mesi ed è stato reperito in un allevamento di maiali in Cina.
Il farmaco, che risale agli anni ’50, non era più usato nell’uomo per la sua tossicità, ma è tornato ad essere utilizzato negli ultimi anni come ultima risorsa vista la perdita di efficacia degli altri. Negli allevamenti però è sempre stato molto usato per favorire la crescita degli animali.
Diversi sono stati gli studi che hanno trovato il gene nel mondo presentati al meeting americano. Una analisi su campioni di 8mila persone in Cina lo ha trovato in 497 campioni, nel 10% dei casi in batteri resistenti anche ad altri antibiotici. Un altro studio cinese ha trovato la mutazione mcr-1 nel 25% dei pazienti in un ospedale a Guangzhou, mentre una analisi in Brasile l’ha trovata nel 60% dei polli da diversi allevamenti brasiliani e nel 98% dei maiali di un campione da diverse zone del Portogallo.
“In alcune aree quasi il 100% degli animali allevati è portatore di mcr-1 – afferma Lance Price della George Washington University -, e anche un numero sempre maggiore di persone. Questo è un esempio classico di come l’uso degli antibiotici negli allevamenti può portare al fenomeno della resistenza nelle infezioni umane”.